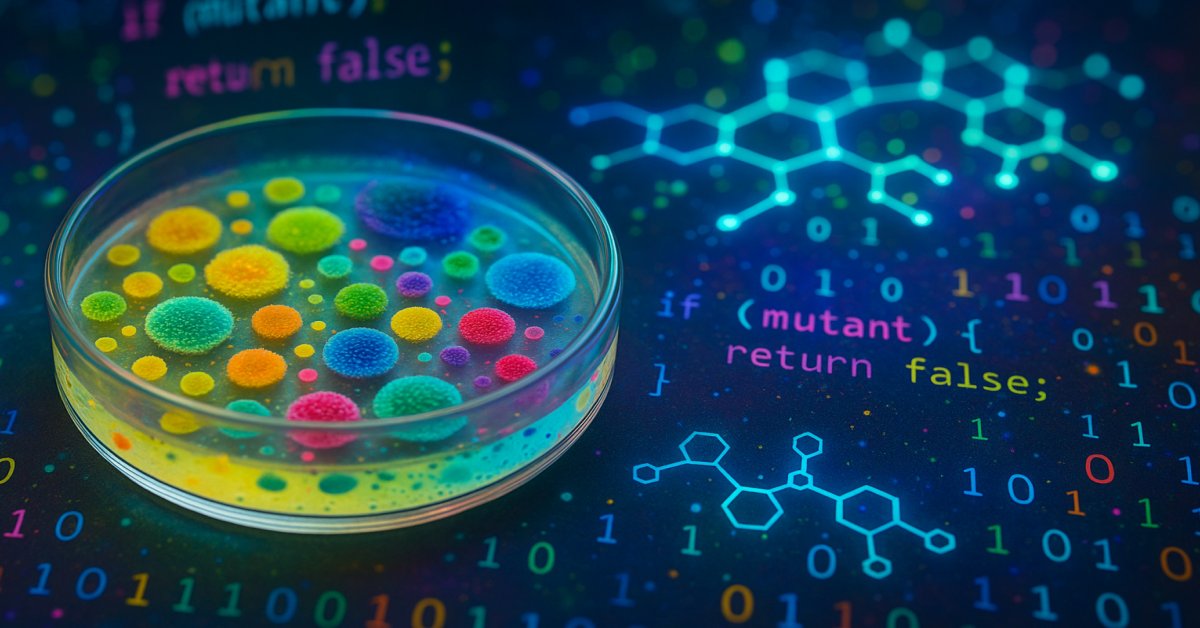

#python_unittest hasil pencarian
uv is the best thing that has happened to Python devs! And you won't find a better cheatsheet than this:

Here's a tiny set of questions that will help you generate unit tests that will actually prevent bugs. What else would you add?

a single unit test i wrote against my +2k -1.5k lines of code PR

🚨 NEW: An open-source Python backtesting framework that runs backtests in 3 lines of Python code. Here's the details: 🧵

"Unit and Integration Test generation for Developers. Generate tests and stubs for your application that actually work!"

🚨 Unlock the Power of Automation: How #Python-PPTX is Revolutionizing Cybersecurity Reporting and Threat Intelligence undercodetesting.com/unlock-the-pow… Educational Purposes!
🚀 Nice uv trick to quickly test dev versions of #Python CLI tools: You can run a repo’s command directly if it matches the repo. E.g. with my tool tisu uvx git+github.com/mgaitan/tisu --help To try a PR, directly add @pull/<PR>/head

uvセットアップしてるんだけどPythonのインストールが爆速で笑った [Python]Windows環境でuvを使った効率的な仮想環境構築!インストールからVS Codeでのデバッグまで|こはた note.com/kohaku935/n/ne…
Unit test gaps in one shot: [pytest -q | codex -p "Given this output, list the top 5 missing tests with minimal repros."] It’s not magic; it’s momentum.
![ShaneSmitas's tweet image. Unit test gaps in one shot:
[pytest -q | codex -p "Given this output, list the top 5 missing tests with minimal repros."]
It’s not magic; it’s momentum.](https://pbs.twimg.com/media/G3tlZxBXgAAG71w.jpg)
Day 18 of python learning. Used functions with input to create a program that can tell if a number is a prime number or not. We keep pushing 😭🤲🤲

[2023-06-25 Sun] I learned how to write tests in pytest dev.to/anoncheg/2023-…
I was doing nothing and I went back to training in the best place to learn and remember... @PentesterLab My code - pentesterlab.com/referral/J8dcc… #bugbounty #pentest

Vertraust du deinen Tests? Dann teste deine Tests. Mit #PIT deckt Julius Mischok auf, wo deine #UnitTests versagen – trotz 100 % Coverage. Mutanten zeigen dir, wo’s weh tut. Lies jetzt: javapro.io/de/teste-deine… #MutationTesting #Java #CleanCode #DevOps #DevTools #JAVAPRO
Here's the full post with a walkthrough on how to create a new tool called `run_tests`, all commands and output shown: ampcode.com/news/more-tool…

Built a one-time password reset, but it's not quite working right... Debug it yourself in the new Thinking in Python course!
.@strickinato @forestfari go behind-the-scenes of our new interactive Python course, where breaking things is expected. With smart autocomplete handling syntax, you focus on the real work: logic, iteration, and debugging. By the end, you’ll have built a cybersecurity system,…
DWHに問い合わせることなく、ローカルでunit testが実行できたら、品質の高い開発がだいぶ捗る データのunit testを手動でやると、色んなダミーデータを持つ上流モデルを用意したりして、結構辛そう #dbt_tokyo
Something went wrong.
Something went wrong.
United States Trends
- 1. Sunderland 59.5K posts
- 2. #UFC321 22.3K posts
- 3. Tosin 11.1K posts
- 4. Chelsea 150K posts
- 5. Delgado 11.8K posts
- 6. Chris Barnett 1,291 posts
- 7. #CollegeGameDay 1,191 posts
- 8. Maresca 18.3K posts
- 9. #OctHealingStreamsDay2 N/A
- 10. Maksum 1,035 posts
- 11. #CHESUN 23.6K posts
- 12. Garnacho 29.7K posts
- 13. Raposo 1,092 posts
- 14. Neto 20.6K posts
- 15. Joao Pedro 10.5K posts
- 16. Nate Bargatze N/A
- 17. Acheampong 5,582 posts
- 18. Hamdy 1,323 posts
- 19. #SaturdayVibes 5,071 posts
- 20. Timothy Mellon 1,995 posts
















![rahul05ranjan's tweet card. [2023-06-25 Sun] I learned how to write tests in pytest](https://pbs.twimg.com/card_img/1979803613502296064/z0ZK2Ihj?format=jpg&name=orig)








